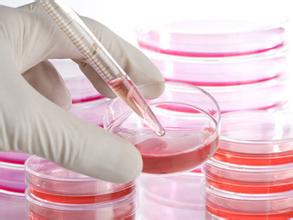

细胞培养技术是细胞学、遗传学、免疫学、实验医学和肿瘤学等多种学科研究的基础实验技术之一。通过细胞培养可以直接观察活细胞的形态结构和生命活动,联合各种技术进行各种物理、化学生物的研究。
一、准备工作
细胞培养的准备工作是很重要,也很复杂的一项工作,应予以重视。
1.无菌室及无菌操作台
无菌操作工作区域应保持清洁及宽敞,必要物品,例如试管架、吸管吸取器或吸管盒等可以暂时放置,其它实验用品用完即应移出,以利于气流之流通。实验用品以70% ethanol擦拭后才带入无菌操作台内。实验操作应在台面之中央无菌区域,勿在边缘之非无菌区域操作。实验进行前,无菌室及无菌操作台(laminar flow) 以紫外灯照射30-60 分钟灭菌,以70% ethanol擦拭无菌操作抬面,并开启无菌操作台风扇运转10 分钟后,才开始实验操作。
2. 实验材料的准备
2.1玻璃器皿的清洗、干燥、消毒:
1)细胞培养的和主要是玻璃容器与pasteur pipet,其它均为塑料无菌制品。
2)实验用的玻璃容器与pasteur pipet使用前都要进行清洗。新购玻璃血清瓶先以0.1~0.05 N HCl 浸泡数小时,洗净后才开始使用。
3)用过之玻璃血清瓶,以高压蒸汽灭菌,洗净后分别用一次与二次去离子水冲洗干净,勿加清洁剂清洗。
4)实验用玻璃血清瓶以铝箔纸包覆瓶盖,高压蒸汽灭菌121℃, 15 lb, 20 分钟,置于oven中烘干。实验用玻璃pasteur pipet以干热灭菌170℃, 4 小时。
2.2培养容器:种类有Tflask,plates, dishes, roller bottle等,依实验需要使用。
2.3 培养基的配制及分装
1)液体培养基贮存于4℃ 冰箱,避免光照,实验进行前放在37℃ 水槽中温热。液体培养基(加血清)存放期为六个月,期间glutamine可能会分解,若细胞生长不佳,可以再添加适量glutamine。
2)粉末培养基(以1 升为例)之配制体积为900 ml,pH为7.2-7.4。NaHCO3 为另外添加,若将NaHCO3粉末直接加入液体培养基中会造成pH之误差,或局部过碱。因此粉末培养基及NaHCO3粉末应分别溶解后才混合,然后用CO2气体调整pH,而非用强酸(HCl)或强碱(NaOH),因为氯离子对细胞生长可能有影响,且贮存时培养基的pH易发生改变。高压灭菌后添加血清。
3)为避免培养基污染,可以在培养基中添加双抗(penicillin 100 units/ml + streptomycin 100 ug/ml)。若实验不或细胞不允许,可将培养基少量分装。操作均在无菌条件下进行。

2.4 抗生素
1)ATCC细胞库之细胞培养基不加抗生素
2)培养自其它实验室引进之细胞株,制作token freeze前培养基须添加抗生素,待token freeze通过污染测试后,大量培养时则不加抗生素。
3)寄送活细胞时,须将培养液充满整个flask时,则须添加抗生素(penicillin 100 units/ml + streptomycin 100 ug/ml)。
4)若要检测mycoplasma,则培养基内不可添加gentamicin,因gentamicin会抑制mycoplasma生长。
5)去除细菌污染之抗生素混合配方:penicillin 250units/ml, streptomycin 250ug/ml, neomycin 250ug/ml, bacitracin 2.5units/ml,注意混合使用后药物毒性会增强。
6)抗生素使用种类与浓度:
| 工作浓度 | 储存温度 | 杀灭细菌 | |
| penicillin | 100 units/ml | -20℃ | G(+) bacteria |
| streptomycin | 100 ug/ml | -20℃ | G(+) and G(-) bacteria |
| chlotetracycline | 50 ug/ml | -20℃ | G(+) and G(-) bacteria |
| gentamicin | 50 ug/ml | -20℃ | G(+) and G(-) bacteria ,mycoplasma |
| amphotericin B | 2.5 ug/ml | -20℃ | yeast and molds |
| nystatin | 50 ug/ml | -20℃ | yeast and molds |
| fungizone | 2.5 ug/ml | -20℃ | yeast and molds |
2.5血清
1)血清必须贮存于–20~–70℃,若存放于4℃,请勿超过一个月。如果一次无法用完一瓶,可将40~45ml 分装于无菌50ml离心管中,由于血清结冻时体积会增加约10 %, 必须预留此膨胀体积之空间,否则易发生污染或容器冻裂之情形。
2)一般厂商提供之血清为无菌,不需再无菌过滤。若发现血清有许多悬浮物,则可将血清加入培养基内一起过滤,勿直接过滤血清。
3)瓶装(500ml) 血清解冻步骤(逐步解冻法):–20℃或–70℃至4℃冰箱溶解一天,至室温下全溶后再分装,一般以50ml无菌离心管可分装40~45 ml。在溶解过程中须规则摇晃均匀(小心勿造成气泡),使温度与成分均一,减少沉淀的发生。勿直接由–20℃直接至37℃解冻,因温度改变太大,容易造成蛋白质凝结而发生沉淀。
3.培养箱及其他仪器的检查与调试
1)CO2钢瓶之CO2压力。
2)CO2培养箱之CO2浓度(5%)、温度(37℃)、及更换水盘的无菌水(可添加消毒剂(Zephrin 1:750)每周更换)。
3)无菌操作台内之airflow压力,定期更换紫外线灯管及HEPA过滤膜,预滤网(300小时/预滤网,3000小时/HEPA)。
4. 其他试剂的配制及灭菌
4.1 PBS(PH7.4,1L):称取8g NaCl、0.2g KCl、1.44g Na2HPO4和0.24g KH2PO4,溶于800ml蒸馏水中,用HCl调节溶液的pH值至7.4,最后加蒸馏水定容至1L即可0.01M 。高压蒸汽灭菌121℃, 15 lb, 20 分钟,室温放冷,置于4℃或常温保存。
4.2 无菌水:双蒸水高压蒸汽灭菌121℃, 15 lb, 20 分钟,室温放冷,常温保存。
二、细胞传代培养
工作人员穿戴实验衣及手套进入无菌室,小心取用实验物品,避免造成污染。勿碰触吸管尖头部或是容器瓶口,亦不要在打开之容器正上方操作实验。容器打开后,以手夹住瓶盖并握住瓶身,倾斜约45°角取用,尽量勿将瓶盖盖口朝上放置桌面。对于来自人类或是病毒感染之细胞株应特别小心操作,并选择适当等级之无菌操作台(至少Class II)。操作过程中,应避免引起aerosol之产生,小心毒性药品,例如DMSO及TPA等,并避免尖锐针头之伤害等。
细胞生长至高密度时,即须分殖至新的培养瓶中,一般稀释比例为1:3 至1:6,依细胞种类而异。具体步骤:
粘附细胞:
1. 吸掉旧培养液。
2. 用PBS洗涤细胞一至二次。
3. 加入trypsin-EDTA 溶液(1ml/25cm2, 2ml/75cm2),37℃作用数分钟,于倒立显微镜下观察,当细胞将要分离而呈现圆粒状时,吸掉trypsin-EDTA溶液。(若不移去trypsin-EDTA,则在trypsin-EDTA作用后,加入适量含血清之新鲜培养基终止trypsin作用,离心后再吸掉上清液)。
4. 轻拍培养瓶使细胞自瓶壁脱落,加入适量之新鲜培养基,以吸管上下吸放数次以打散细胞团块,混和均匀后,依稀释比例转移至新的培养瓶中,以正常培养条件培养。
悬浮细胞:
1. 吸出细胞培养液,放入离心管中,离心1000 rpm 5 分钟。
2. 吸掉上清液,加入适量之新鲜培养基,混和均匀后,依稀释比例转移至新的培养瓶中,以正常培养条件培养。

三、细胞冷冻保存
步骤:
1. 冷冻前一日前更换半量或全量培养基,观察细胞生长情形。
2. 配制冷冻保存溶液(使用前配制):将DMSO加入新鲜培养基中,最后浓度为5-10%,混合均匀,置于室温下待用。
3. 按细胞传代培养操作,收集培养之细胞,取少量细胞悬浮液((约0.1 ml)计数细胞浓度及冻前存活率。
4. 离心,去除上清液,加入适量冷冻保存溶液,使细胞浓度为1-5 x 106 cells/ml,混合均匀,分装于已标示完全之冷冻保存管中,1 ml/vial,并取少量细胞悬浮液作污染检测。
5. 冷冻保存方法1: 冷冻管置于4℃ 10 分钟→ -20℃ 30分钟→ -80℃ 16~18小时(或隔夜)→液氮槽vapor phase长期储存。
6. 冷冻保存方法2: 冷冻管置于含异丙醇的程序降温盒中,直接放入-80℃,1~2天后再放入液氮槽中。
|
细胞类型 |
冻存浓度(cells/ml) |
|
normal human fibroblast |
1~3*106 |
|
hybridoma |
1~3 x 106 |
|
adherent tumor lines |
5~7 x 106 |
|
HeLa |
1-3 x 106 |
|
other suspensions |
5~10 x 106 |
注意事项:
1. 欲冷冻保存的细胞应在生长良好且存活率高之状态,约为80–90%致密度。
2. 冷冻前检测细胞仍保有其特有性质。
3.冷冻保护剂DMSO应为试剂级等级,无菌且无色,以5~10 ml小体积分装,4℃避光保存,勿作多次解冻。Glycerol 亦应为试剂级等级,以高压蒸汽灭菌后避光保存。在开启后一年内使用,因长期储存后对细胞会有毒性。
4. 冷冻保护剂浓度为5或10% DMSO,若是不确定细胞之冷冻条件,在做冷冻保存之同时,亦应作一个backup culture,以防止冷冻失败。
四、细胞复苏
步骤:
1. 从液氮容器中取出冻存管,直接浸入37℃温水中,并不时摇动令其尽快融化。
2. 从37℃水浴中取出冻存管,打开盖子,用吸管吸出细胞悬液,加到离心管并滴加10倍以上培养液,混匀;
3. 离心, 1000rpm,5min;
4. 弃去上清液,加入含10%小牛血清培养液重悬细胞,计数,调整细胞密度,接种培养瓶,37℃培养箱静置培养;
5. 次日更换一次培养液,继续培养。
注意事项:
1 操作人员应戴防护面罩及手套,防止冷冻管可能爆裂之伤害。
2 自液氮或干冰容器中取出冷冻管,检查盖子是否旋紧,由于热胀冷缩过程,此时盖子易松掉。
3 将新鲜培养基置于37℃水槽中回温,回温后喷以70 % 酒精并擦拭之,移入无菌操作台内。
五、细胞计数与存活测试
1.存活测试之步骤为dye exclusion,利用染料会渗入死细胞中而呈色,而活细胞因细胞膜完整,染料无法渗入而不会呈色。一般使用蓝色之trypan blue染料,如果细胞不易吸收trypan blue,则用红色之Erythrosin bluish。
2. 步骤:
2.1. 取50µl细胞悬浮液与50µl trypan blue (or Erythrosin bluish)等体积混合均匀于1.5ml小离心管中。
2.2. 取少许混合液(约15µl) 自细胞计数版上方凹槽加入,于100倍倒立显微镜下观察,或于细胞计数仪中自动检测活细胞不染色,死细胞则为蓝色(或红色- Erythrosinbluish)。
2.3. 计数四个大方格之细胞总数,再除4,乘以稀释倍数(至少乘以2,因与trypan blue等体积混合),最后乘以104,即为每ml中细胞悬浮液之细胞数。若细胞位于线上,只计上线与右线之细胞(或计下线与左线之细胞)。
4 大格*细胞总数x 2 x 104/4= 细胞数/m
英格恩生物技术博客 生物实验干货分享